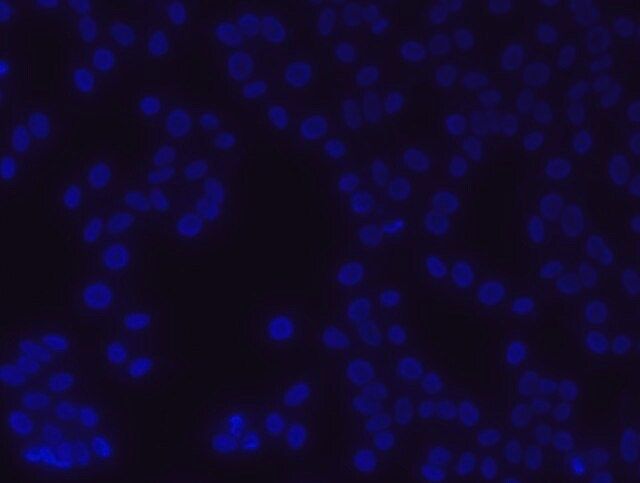

您的位置:首页 > 产品中心 > 28718-90-3, 4',6-二脒基-2-苯基吲哚 二盐酸盐
产品中心
4',6-二脒基-2-苯基吲哚 二盐酸盐
DAPI ready made solution with Antifade
| 产品编号: | 4117720 |
| 规格: | For Nuclear counterstain in Fluorescence Microscopy |
| CAS NO: | 28718-90-3 |
| 包装规格: | 10 ML |
| 产品类别: | 进口试剂 |
| 品牌: | Sigma-Aldrich |
| 优惠价: | 立即咨询 |
产品价格查看更多规格...
| 产品编号 | 包装单位 | 单价(元) | 国内现货 | 国外库存 | 询价单 |
| 4117720 | 10 ML | 1450 |
产品别名
28718-90-3
4',6-二脒基-2-苯基吲哚 二盐酸盐
DAPI ready made solution with Antifade
2-(4-Amidinophenyl)-6-indolecarbamidine dihydrochloride
DAPI Stain
DAPI Dye
DNA Content Counterstain
4′,6-Diamidino-2-phenylindole dihydrochloride
DAPI dihydrochloride
DAPI 二盐酸盐
2-(4-氨基苯基)-6-吲哚甲酰胺 二盐酸盐
结构式
基本信息
| Empirical Formula【经验(实验)分子式】 | C16H15N5 · 2HCl |
| Molecular weight | 350.25 |
| Beilstein | 4894417 |
| MDL number | MFCD00012681 |
| General description【一般描述】 | DAPI, 4′,6-diamidino-2-phenylindole, is a blue fluorescent nucleic acid stain that fluoresces brightly upon selectively binding to the minor groove of double stranded DNA. Its selectivity for DNA and high cell permeability allows efficient staining of nuclei with little background from the cytoplasm. The excitation and emission wavelengths of DAPI-DNA complex are 360 nm and 460 nm, respectively. Most of the fluorescent dyes fade (photobleach) when exposed to excitation light. The amount of photobleaching depends on the composition of the molecule and the time of light exposure. DAPI Ready Made Solution with Antifade is a formulation that suppress photobleaching and prolong fluorescent signals. |
| Application【应用】 | DAPI Ready Made Solution with Antifade is a glycerol based ready to use solution provided at 1μg/mL concentration in a dropper vial that can be applied directly to cells or tissue samples on microscope slides or coverslips. It is recommended to warm up at room temperature and mix by swirling the dropper vial before use. Store DAPI Ready Made Solution with antifade at -20 C protected from light. 在琼脂糖凝胶中染色DNA,DAPI比溴化乙锭敏感几倍。它可用于DNA的光足迹图谱,通过对双链复合体的特殊可视化检测印迹应用中的退火探针,并使用流式细胞分析术研究DNA中的变化并分析凋亡过程中的DNA含量。DAPI染色也是一种敏感和特异的支原体检测方法。 |
| Biochem/physiol Actions【生化/生理作用】 | DNA的细胞渗透性荧光小沟结合探针。与双链DNA的小沟(富含AT的DNA优先)结合,形成稳定的复合物,其发出的荧光比单独的DAPI高约20倍。 |
| Features and Benefits【特点和优势】 |
|
| Physical form【外形】 | Liquid - DAPI readymade with antifade solution is provided at 1μg/mL concentration in glycerol-PBS based solution. |
产品性质
| form【形式】 | liquid |
| storage condition【储存条件】 | protect from light |
| technique(s) | transfection: suitable |
| fluorescence【荧光】 | λex 340 nm; λem 488 nm (nur DAPI) λex 364 nm; λem 454 nm (DAPI-DNA-Komplex) |
| shipped in【运输】 | dry ice |
| storage temp.【储存温度】 | −20℃ |
| SMILES string | Cl.Cl.NC(=N)c1ccc(cc1)-c2cc3ccc(cc3[nH]2)C(N)=N |
| InChI | 1S/C16H15N5.2ClH/c17-15(18)10-3-1-9(2-4-10)13-7-11-5-6-12(16(19)20)8-14(11)21-13;;/h1-8,21H,(H3,17,18)(H3,19,20);2*1H |
| InChI key | FPNZBYLXNYPRLR-UHFFFAOYSA-N |
安全信息
| Hazard Statements | H412 |
| Precautionary Statements | P273 - P501 |
| Hazard Classifications【危险分类】 | Aquatic Chronic 3 |
| Storage Class Code【储存分类代码】 | 10 - Combustible liquids |
| WGK | WGK 2 |





